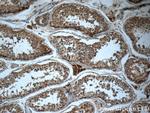
HEATR4 Antibody in Immunohistochemistry (Paraffin) (IHC (P))

Search
Proteintech
HEATR4 Polyclonal Antibody
{{$productOrderCtrl.translations['antibody.pdp.commerceCard.promotion.promotions']}}
{{$productOrderCtrl.translations['antibody.pdp.commerceCard.promotion.viewpromo']}}
{{$productOrderCtrl.translations['antibody.pdp.commerceCard.promotion.promocode']}}: {{promo.promoCode}} {{promo.promoTitle}} {{promo.promoDescription}}. {{$productOrderCtrl.translations['antibody.pdp.commerceCard.promotion.learnmore']}}
产品信息
23944-1-AP
种属反应
宿主/亚型
分类
类型
抗原
偶联物
形式
浓度
规格
纯化类型
保存液
内含物
保存条件
运输条件
产品详细信息
Immunogen sequence: NKEVRRAAA QALGQMSLGK EVHDIIRVKL GQGNSQERVE ALYLIGELKL MTAKLLPSFL HCFSDDFTAV RRAACLAAGA LQIRDKMVLE CLLNLMQRDP YWKIKAFAIR ALGQIGQVSP ELTDLLLWAI HYEESPGVRL EACRSILALK LQGDRVRDTF LDVLLLENHD AVLKEMYQTM KILNLGNEGN QEMLQEIKNR IKTLSQKDLL THKILKLEMV MGKVREEAKR VYLKPKGEQG PLTLQTLLQE TFQDEMVLPR RPSEVCDTEA VIKPVKPRAP NPWLQSSVPG LTTRSKVRSS LVKDLRTSPE KRIAVGPFRS DYPALYLGKF SERTFFSPIM SSPSGKKGAH L (678-1026 aa encoded by BC047590)
靶标信息
HEATR4 is a protein coding gene.
仅用于科研。不用于诊断过程。未经明确授权不得转售。
篇参考文献 (0)
生物信息学
蛋白别名: HEAT repeat-containing protein 4; unnamed protein product
基因别名: HEATR4
UniProt ID: (Human) Q86WZ0
Entrez Gene ID: (Human) 399671